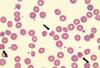
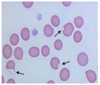
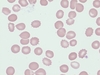

If a patient were suffering from appendicitis, you would expect which cells to be increased in the peripheral blood?
neutrophils
Which cells make up the biggest mass of cells in the peripheral blood?
erythrocytes
These cells are important in maintaining normal hemostasis.
platelets
A patient has a WBC count of 25 x 10%/L. The doctor subsequently orders a differential count. This is an example of
reflex testing
The pre-examination component of laboratory testing includes:
storage, collection
A decrease in erythrocytes is accompanied by a decrease in:
hemoglobin (and hematocrit)
Laboratory screening tests include all of the following except:
A. bone marrow examination
B. WBC count
C. prothrombin time
D. RBC indices
bone marrow examination
An increase in the concentration of neutrophils in the peripheral blood is most commonly due to:
infection
An upset in the balance of coagulation proteins can result in a defect of:
hemostasis
Apoptosis is best described as:
programmed cell death
What are considered to be initiators of apoptosis?
growth factor withdrawal
loss of attachment to extracellular matrix
cell-damaging stress
(A. growth factor withdrawal, B. loss of attachment to extracellular matrix, C. cell-damaging stress)
All of the following are events regulated by apoptosis EXCEPT:
A. elimination of auto reactive lymphocytes
B. elimination of expanded lymphocytes following cessation of immune response
C. elimination of expanded erythrocytes following cessation of hypoxic episode
D. elimination of expanded phagocytic cells following cessation of infection/inflammatory response
elimination of expanded erythrocytes following cessation of hypoxic episode
The proteosome is:
a protease complex used for destruction of ubiquitin-labeled molecules
The cell-cycle regulatory protein that functions to inhibit cell cycling by sequestering transcription factors required for cell-cycle progression from G1/S is:
Rb
The protein responsible for monitoring DNA damage and the integrity of the genome is:
p53
All of the following are considered diseases associated with increased apoptosis EXCEPT:
A. aplastic anemia
B. AIDS
C. Parkinson’s disease
D. systemic lupus erythematosus
E. toxic induced liver disease
D. systemic lupus erythematosus
Also: cancers, other autoimmune disorders and viral infections
How would you differentiate between basophilic stippling and Pappenheimer bodies in a Wright’s-stained blood smear?
B. Stain another blood smear with Prussian blue
Pappenheimer bodies are identified with prussian blue
How can basophilic stippling be differentiated from polychromasia?
Basophilic stippling stains as blue-black granules whereas polychromasia stains a diffuse pinkish-gray on the Wright’s stain
Upon review of a stained blood smear you note that erythrocytes appear to form irregular clusters, like grapes. How would you report this?
RBC agglutination noted
In a child with hemoglobin M, what would you expect to find?
A leftward shift on the ODC
- methemoglobin is ferric (Fe3+) which cannot bind oxygen, so the other heme groups bind it more tightly as a result, and they do not want to give it up to the tissues, causing hypoxia
What do decreased haptoglobin and hemopexin levels indicate?
increased intravascular RBC destruction
Which statement about RBC catabolism and hemoglobin dissociation is NOT true?
A. Released iron is transported in plasma by haptoglobin back to the marrow.
B. Globin is catabolized to amino acids that enter the amino acid pool.
C. Porphyrin rings are broken, producing carbon monoxide and biliverdin.
D. Bilirubin is carried to the liver, conjugated, and excreted in the bile.
A. Released iron is transported in plasma by haptoglobin back to the marrow
In which cellular location does the insertion of iron into the protoporphyrin ring take place?
mitochondria
When should hemoglobin electrophoresis be considered?
methemoglobinemia